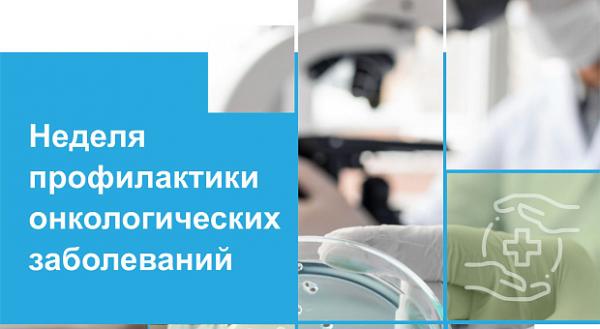

Муниципальное автономное дошкольное образовательное учреждение
Центр развития ребенка – детский сад «Лира»
618120, Пермский край, Осинский район,
город Оса, улица Ленина 34
+7 342 914 81 93
lira-osa@dou.permkrai.ru
4 февраля ежегодно отмечается Всемирный день борьбы против рака. Во многих странах по всему миру проходят мероприятия, посвященные повышению осведомленности граждан об онкозаболеваниях, способах их профилактики, диагностики, лечения и факторах риска их развития.
4 февраля ежегодно отмечается Всемирный день борьбы против рака. Во многих странах по всему миру проходят мероприятия, посвященные повышению осведомленности граждан об онкозаболеваниях, способах их профилактики, диагностики, лечения и факторах риска их развития.
Не так давно диагноз «рак» воспринимался как приговор, а каждый случай выздоровления — как чудо. Сейчас ситуация изменилась: постоянно появляются новые методы лечения, препараты, подходы к терапии и диагностике. Профильные медицинские учреждения оснащаются современным оборудованием для диагностики и лечения пациентов, что позволяет обнаруживать онкозаболевания на ранних стадиях, когда они излечимы в 90% случаев.
Последние достижения науки и медицинской практики позволили значительно продвинуться в лечении злокачественных новообразований.
Можно ли избежать онкологического заболевания? Согласно многочисленным исследованиям, генетика и ряд других факторов, не зависящих от нас, способствуют развитию заболевания лишь в 30% случаев.
Сократить риск развития рака возможно, если придерживаться правилам здорового образа жизни:
1.Здоровое питание и поддержание веса. Избыточный вес и ожирение являются факторами риска развития многих злокачественных опухолей, в том числе рака молочной железы и рака матки.
2. Исключение потребления алкоголя. Установлено, что алкоголь является одним из факторов риска развития рака полости рта, пищевода, печени и молочной железы.
3. Отказ от курения. Курение является фактором развития рака легкого, ротовой полости, пищевода, поджелудочной железы, желудка и др.
4. Защита от инфекций. Вирус папилломы человека (ВПЧ) способствует развитию онкологических заболеваний половой сферы.
5. Защита от ионизирующего и ультрафиолетового излучения. Ультрафиолетовое и ионизирующее излучения являются причиной возникновения онкологических заболеваний кожи.
6.Оптимальная физическая активность. Физически активные люди имеют более низкий риск развития некоторых злокачественных новообразований.
Для того чтобы выявить онкологические заболевания, когда еще нет симптомов, необходимо пройти диспансеризацию, ведь онкологические заболевания, обнаруженные на ранней стадии, излечимы в 90% случаев.
Во время диспансеризации проводится онкоскрининги на выявление рака шейки матки, в более старшем возрасте к ним добавляются скрининги для обнаружения колоректального рака, рака желудка, двенадцатиперстной кишки, молочной и предстательной желез.
При подозрении на онкозаболевание пациента отправляют на консультацию с профильным врачом и дообследование, при котором применяются различные методы исследования: колоноскопия, гастроскопия, дерматоскопия и др., а также консультации врачей-специалистов. Для более углубленного обследования человека направляют на консультацию к врачу-онкологу.
Благодаря регулярной проверке организма и исследованиям состояния внутренних органов во время диспансеризации онкологические заболевания удается выявить на ранних стадиях, в таком случае объем противоопухолевой терапии зачастую гораздо меньше, переносится легче, а прогноз наиболее благоприятен.
Каждый человек мечтает прожить долгую жизнь и избежать серьезных болезней, нарушающих уклад жизни, ограничивающих повседневную активность, требующих продолжительного интенсивного лечения. Придерживаясь принципов здорового образа жизни, своевременное прохождение диспансеризации позволит значительно снизить вероятность развития онкологического заболевания.









